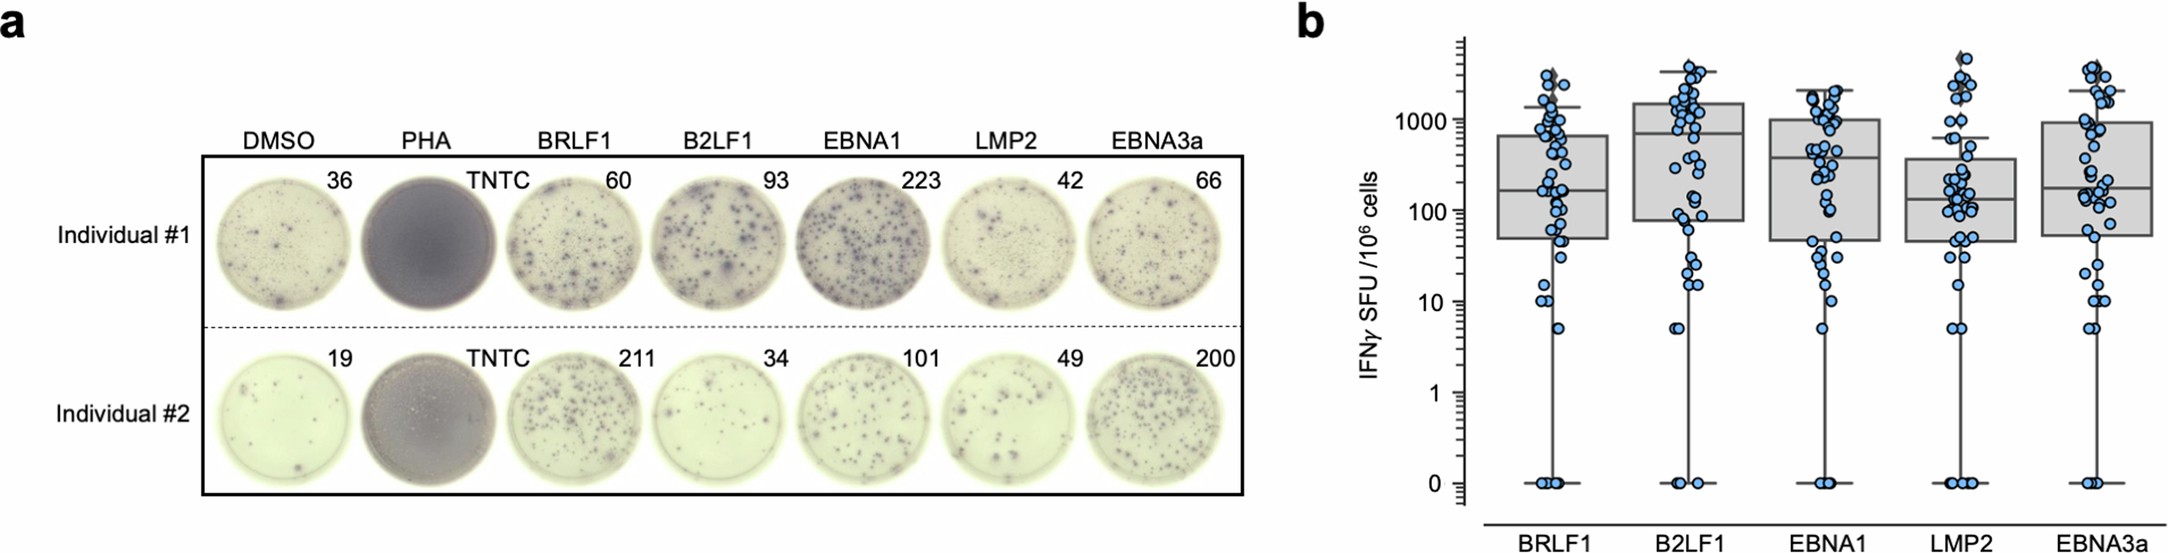
Extended Data Fig. 5: Response of individuals in cohort to overlapping peptide pools from Epstein-Barr Virus (EBV) proteins.

Extended Data Fig. 5: Response of individuals in cohort to overlapping peptide pools from Epstein-Barr Virus (EBV) proteins.
(a) Representative IFN-γ ELISpot assays for representative HLA-haplotyped individuals in cohort using overlapping peptide pools from EBV proteins BRLF1, B2LF1, EBNA1, LMP2 and EBNA3a. DMSO was used as a negative control and phytohemagglutinin-L (PHA) was used as a positive control. TNTC: Too Numerous To Count. (b) Summary data for ELISpot data for all individuals in cohort (n = 50 peptides per protein). Box plots are presented with medians as center lines, 25th and 75th percentiles as lower and upper quartiles, and 1.5 x interquartile range from the quartiles as whiskers (outliers not shown).